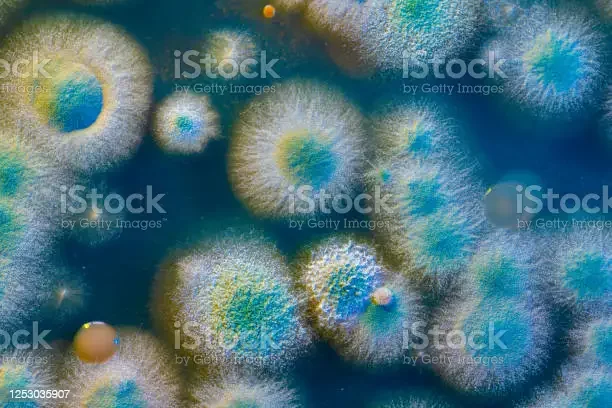
Penicilina

-
 El motor de vapor permitió una expansión nunca antes vista y con ella se terminó de colonizar gran parte del planeta, además el comercio creció y la globalización continúo germinando en las nuevas redes existentes.
El motor de vapor permitió una expansión nunca antes vista y con ella se terminó de colonizar gran parte del planeta, además el comercio creció y la globalización continúo germinando en las nuevas redes existentes. -
 Volta inventó la primera bateía o generador electroquímico capaz de producir una corriente eléctrica mantenida en el tiempo, por ello fue conocida como pila voltaica
Volta inventó la primera bateía o generador electroquímico capaz de producir una corriente eléctrica mantenida en el tiempo, por ello fue conocida como pila voltaica -
 La máquina de escribir es un dispositivo mecánico, electromecánico o electrónico, con un conjunto de teclas que, al ser presionadas, imprimen caracteres en un documento, normalmente papel. La persona que opera una máquina de escribir recibe el nombre de mecanógrafo.
La máquina de escribir es un dispositivo mecánico, electromecánico o electrónico, con un conjunto de teclas que, al ser presionadas, imprimen caracteres en un documento, normalmente papel. La persona que opera una máquina de escribir recibe el nombre de mecanógrafo. -
 los hermanos Wright cumplieron uno de los sueños del ser humano: volar. Pero más allá de conseguir una quimera, lograron crear una forma de transporte más rápida capaz de unir distancias que, hasta ese momento, eran demasiado lejanas. Desde entonces, la industria aeronáutica se ha ido desarrollando con rapidez. Sus usos pasan del transporte de personas y mercancías a otros fines como el bélico.
los hermanos Wright cumplieron uno de los sueños del ser humano: volar. Pero más allá de conseguir una quimera, lograron crear una forma de transporte más rápida capaz de unir distancias que, hasta ese momento, eran demasiado lejanas. Desde entonces, la industria aeronáutica se ha ido desarrollando con rapidez. Sus usos pasan del transporte de personas y mercancías a otros fines como el bélico. -
Alexander Fleming descubrió la penicilina, un compuesto químico con propiedades antibióticas. Gracias a su existencia han sido innumerables vidas las que han sido salvadas. De hecho, con su aparición, enfermedades que hasta entonces eran consideradas mortales dejaron de serlo.
Alexander Fleming descubrió la penicilina, un compuesto químico con propiedades antibióticas. Gracias a su existencia han sido innumerables vidas las que han sido salvadas. De hecho, con su aparición, enfermedades que hasta entonces eran consideradas mortales dejaron de serlo. -
 Usar energía de microondas para cocinar alimentos produjo un cambio sísmico en la forma de preparar la comida, progresivamente se fue extendiendo a todo el mundo, hasta convertirse en uno de los electrodomésticos más populares del siglo XX.
Usar energía de microondas para cocinar alimentos produjo un cambio sísmico en la forma de preparar la comida, progresivamente se fue extendiendo a todo el mundo, hasta convertirse en uno de los electrodomésticos más populares del siglo XX. -
 El nacimiento del Internet se le debe a ARPAnet o Red de la Agencia para los Proyectos de Investigación Avanzada de los Estados Unidos, fue en 1969 cuando Charley Kline estudiante de UCLA envió un mensaje de una computadora a otra que se encontraba a 500km de distancia, la palabra que él quería enviar era LOGIN, pero solo logro enviar una parte de ella ya que los equipos se colapsaron, fue así como nació lo que hoy conocemos como Internet.
El nacimiento del Internet se le debe a ARPAnet o Red de la Agencia para los Proyectos de Investigación Avanzada de los Estados Unidos, fue en 1969 cuando Charley Kline estudiante de UCLA envió un mensaje de una computadora a otra que se encontraba a 500km de distancia, la palabra que él quería enviar era LOGIN, pero solo logro enviar una parte de ella ya que los equipos se colapsaron, fue así como nació lo que hoy conocemos como Internet. -
 El famoso juego Pac-Man salió a la luz, también conocido como Comecocos, fue creado por Toru Iwatani, llego a tener récord guines como el juego más exitoso en los años 1981 a 1987.
El famoso juego Pac-Man salió a la luz, también conocido como Comecocos, fue creado por Toru Iwatani, llego a tener récord guines como el juego más exitoso en los años 1981 a 1987. -
 David Packard y William Hewlett fundan en el garaje de una casa Hewlett Packard, en los años 80 HP se convirtió en el mayor fabricante de electrónicos en el mundo, hoy en día HP es una de los fabricantes de computo más reconocidos en el mundo.
David Packard y William Hewlett fundan en el garaje de una casa Hewlett Packard, en los años 80 HP se convirtió en el mayor fabricante de electrónicos en el mundo, hoy en día HP es una de los fabricantes de computo más reconocidos en el mundo. -
 Se conoce como el primer navegador web gráfico que funciono con Windows, fue creado en el año de 1993, la primera versión de esta función en Unix y fue tanto su éxito que se crearon versiones para Microsoft Windows Y Macintosh.
Se conoce como el primer navegador web gráfico que funciono con Windows, fue creado en el año de 1993, la primera versión de esta función en Unix y fue tanto su éxito que se crearon versiones para Microsoft Windows Y Macintosh.
Plan projects on a visual timeline
Map milestones, phases, deadlines, and key events in one place so the sequence is easier to see and share. Timetoast is a timeline maker for work, school, research, and stories.